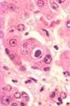
Faringite. Giovanni Di Bonaventura, Ph.D. CI Medicina di Laboratorio CL Medicina e Chirurgia Università G. d Annunzio di Chieti-Pescara AA 2014-2015

BD Group B Streptococcus Differential Agar (Granada Medium)
|
|
|
- Sergio Berto Brunelli
- 9 anni fa
- Просмотров:
Транскрипт
1 PA Pagina 1 di 5 ISTRUZIONI PER L'USO TERRENI SU PIASTRA PRONTI PER L'USO PA Rev.: Apr 2013 USO PREVISTO (agar differenziale per streptococco di gruppo B) è usato per l isolamento e l identificazione dello Streptococcus agalactiae (Streptococcus di gruppo B) da campioni clinici. PRINCIPI E SPIEGAZIONE DELLA PROCEDURA Metodica microbiologica. Lo Streptococcus agalactiae provoca infezioni neonatali gravi, incluse setticemia, meningite e infezioni a carico di più organi. 1-3 Il neonato viene infettato dalla madre, che può essere portatrice asintomatica dell'organismo nella flora vaginale. L'incidenza di infezione è di circa 1,5 ogni 1000 nati vivi e la mortalità è dell'8,7% circa. 3 È stato dimostrato che l'opportuna rilevazione dell'agente nella flora vaginale delle donne in gravidanza, seguita dal corretto trattamento del neonato, può ridurre in modo notevole il rischio di infezione. 2,3 La tecnica standard per l'isolamento da campioni vaginali è basata sull'uso di agar sangue o di agar sangue selettivo e sulla rilevazione della beta-emolisi caratteristica, seguita dall'identificazione biochimica o sierologica. 1 Recenti ricerche hanno dimostrato che anche bassi livelli di S. agalactiae nella flora vaginale possono mettere il neonato a rischio di infezione. Sono quindi consigliate tecniche di arricchimento come il LIM Broth. 4 Questo terreno di arricchimento non è tuttavia completamente selettivo per S. agalactiae, ed è quindi possibile che altri organismi Gram-positivi vengano arricchiti da questo metodo, con possibile conseguente occultamento di S. agalactiae. Negli ultimi anni, sono state esaminate modificazioni del terreno Islam, descritto nel 1977, per determinarne l'idoneità per la rilevazione e l'isolamento dell'organismo. 5,6 Su questi terreni, come sul terreno New Granada (una recente modificazione del terreno Islam), i ceppi beta-emolitici di S. agalactiae producono colonie di colore da arancio a salmone. 7,8 La colorazione della colonia è dovuta al pigmento proprio dell organismo: granadaene, un'ornitina rhamno-poliene). 16 La pigmentazione è altamente specifica e non si verifica con streptococchi non appartenenti al gruppo B o con altri organismi. Tuttavia, il terreno New Granada ha una stabilità limitata. 9,10 In, una modificazione del terreno New Granada con migliore stabilità e selettività, il peptone proteosico n. 3 è una fonte proteica e fornisce i precursori necessari per la produzione e la crescita dei pigmenti. L'amido è una sostanza nutriente e agisce come stabilizzatore del pigmento. Il glucosio, il piruvato e la cisteina sono sostanze nutrienti. Il magnesio è un micronutriente. La combinazione di MOPS e di fosfato agisce come un tampone del ph. Il cristalvioletto inibisce gli stafilococchi. Inibitori e stimolatori sono stati aggiunti per sopprimere la flora associata, come i batteri Gram-negativi e gli anaerobi stretti e per migliorare la formazione del pigmento. REAGENTI Formula* per litro di acqua purificata Peptone proteosico n. 3 25,0 g Idrogenofosfato disodico 10,7 g Amido di granoturco 14,0 Cristalvioletto 0,0005 Glucosio 2,5 Inibitori e stimolatori 0,021 Acido piruvico, sale sodico 1,0 Agar 15,2 Cloridrato di cisteina 0,1 Solfato di magnesio 0,3 MOPS (acido 3-morfolino 11,0 propansulfonico), sale semisodico ph 7,4 ± 0,2 *Formulazione aggiustata e/o supplementata per soddisfare i criteri prestazionali.
2 PRECAUZIONI. Solo per uso professionale. Non usare le piastre se presentano segni di contaminazione microbica, discromia, essiccamento, crepe o altri segni di deterioramento. Per dettagli su procedure di manipolazione asettica, biorischi e smaltimento di prodotti usati, consultare le ISTRUZIONI GENERALI PER L'USO. CONSERVAZIONE E VITA UTILE Alla consegna, conservare le piastre al buio a 2 8 C nella confezione originale fino al momento dell uso. Evitare congelamento e surriscaldamento. Le piastre possono essere inoculate sino alla data di scadenza (vedere l'etichetta della confezione) e incubate per i tempi di incubazione raccomandati. Le piastre prelevate da confezioni da 10 già aperte possono essere usate per una settimana, se conservate in luogo pulito a 2 8 C. CONTROLLO DI QUALITÀ A CURA DELL'UTENTE Inoculare i campioni rappresentativi con i ceppi di seguito elencati (per informazioni più dettagliate, vedere il documento ISTRUZIONI GENERALI PER L'USO). Incubare in anaerobiosi per h a 35 2 C. Ceppi Streptococcus agalactiae ATCC Streptococcus pyogenes ATCC Enterococcus faecalis ATCC Staphylococcus aureus ATCC Bacteroides fragilis ATCC Proteus mirabilis ATCC Non inoculati Risultati della crescita Crescita da buona a eccellente, colonie piccole-medie colore arancio, con o senza bordi incolori Crescita; colonie piccolissime da incolori a grigie Crescita; colonie medie da incolori a grigie Inibizione completa Inibizione da parziale a completa Inibizione da parziale a completa, sciamatura completamente inibita, colonie incolori Da bianco a grigiastro chiaro, opaco PROCEDURA Materiali forniti (piastre Stacker da 90 mm). Microbiologicamente controllato. Materiali non forniti Terreni di coltura accessori, reagenti e apparecchiature di laboratorio necessarie. Tipi di campioni può essere usato per l'isolamento di S. agalactiae (streptococchi di gruppo B) da tutti i tipi di campioni clinici umani. Campioni comuni includono tamponi del tratto genitale femminile o tamponi e altri campioni provenienti da neonati. Per il prelievo e il trasporto dei campioni, adottare le tecniche adatte. 1,11 Procedura del test Strisciare il campione appena pervenuto in laboratorio su BD Group B Streptococcus Differential Agar (Granada Medium). La piastra con lo striscio viene prevalentemente usata per isolare colture pure da campioni contenenti flora mista. In alternativa, se il materiale viene posto in coltura direttamente da un tampone, passare il tampone su una piccola area del bordo e strisciare dalla zona inoculata per isolare le colonie. Incubare in anaerobiosi a 35 2 C per h. Se le piastre risultano negative, possono essere incubate per un ulteriore periodo di h, sebbene ciò non sia generalmente necessario. Allo scopo di rilevare tutti i patogeni associati a un'infezione o a una colonizzazione, il campione va anche strisciato su una piastra di agar sangue, come BD Columbia Agar with 5% Sheep Blood, che va quindi incubata in atmosfera arricchita con CO 2 per h a 35 2 C. Se si usano terreni di prearricchimento in forma liquida come il Lim Broth, è possibile PA Pagina 2 di 5
3 eseguirne la subcoltura su con un'ansata di brodo dopo h di incubazione e quindi incubarli come sopra descritto. Risultati Dopo l'incubazione, i ceppi beta-emolitici di S. agalactiae producono colonie da piccole a medie, di colore arancio da chiaro a intenso o di colore salmone-arancio con possibili bordi incolori. Per rilevare i ceppi con pigmentazione debole, è necessario leggere le piastre su fondo bianco. Una pigmentazione di colore arancio, di qualsiasi intensità, deve essere considerata positiva. Per la lettura, non porre le piastre di fronte a una sorgente luminosa. Gli stafilococchi, i bacilli Gramnegativi e gli anaerobi stretti vengono generalmente completamente inibiti sul terreno. Altri streptococchi ed enterococchi crescono per lo più senza essere inibiti, ma producono colonie da incolori a grigie. Ceppi non emolitici di S. agalactiae producono anche colonie da grigie a grigioblu. La loro incidenza è bassa (fino a 4% in donne in gravidanza). Per differenziare gli streptococchi di gruppo B non emolitici dagli enterococchi o dagli streptococchi di altri gruppi, un test PYR (utilizzare BD DrySlide PYR kit, n. di cat ) può essere eseguito direttamente da colonie grigie a colonie grigio-blu su BD Group B Streptococcus Differential Agar (Granada Medium): enterococchi, Streptococcus pyogenes e diversi altri streptococchi sono PYR-positivi (=colore da rosso a viola entro 1 min), mentre S. agalactiae e una gamma di altri streptococchi sono PYR-negativi (=da giallastro a incolore). 15 Gli isolati con risultati PYR-negativi da colonie grigie o grigio-blu devono essere sottoposti a ulteriori test per confermare la presenza di un ceppo non emolitico di S. agalactiae, ad es. mediante la tipizzazione sierologica. La pigmentazione colore arancio su questo terreno è altamente specifica per S. agalactiae e l'identificazione sierologica o biochimica non è necessaria per la conferma. È tuttavia possibile eseguire la tipizzazione sierologica direttamente da BD Group B Streptococcus Differential Agar (Granada Medium) senza ulteriori subcolture. A questo scopo, è possibile utilizzare il BBL Streptocard Enzyme Latex Test Kit (n. di cat ). Inoltre, è necessario esaminare la piastra BD Columbia Agar with 5% Sheep Blood per rilevare l'eventuale presenza di ceppi non emolitici di S. agalactiae e di ulteriori patogeni. CARATTERISTICHE PRESTAZIONALI E LIMITAZIONI DELLA PROCEDURA è usato per l'isolamento e l'identificazione dello Streptococcus agalactiae (streptococco di gruppo B) da tutti i tipi di campioni clinici umani. La colorazione arancio della colonia su questo terreno è altamente specifica per S. agalactiae (vedere Caratteristiche prestazionali): test di conferma non sono quindi necessari. In caso di dubbio o nel caso di ceppi con pigmentazione debole, è possibile eseguire la tipizzazione sierologica e/o un test PYR direttamente dalla piastra di isolamento. È stato riportato che i geni responsabili per la produzione dei pigmenti e per la produzione dell'emolisina di S. agalactiae sono geneticamente correlati. 12,13 L'1 2% circa dei ceppi di S. agalactiae non è emolitico 14 e, di conseguenza, può non produrre alcuna pigmentazione su BD Group B Streptococcus Differential Agar (Granada Medium). Tuttavia, è stato determinato internamente che i produttori deboli di emolisina che sembrano non emolitici sulla maggior parte dei terreni agar sangue possono essere produttori deboli di pigmenti. L'emolisina è stata giudicata come uno dei principali fattori di patogenicità di S. agalactiae. 12,13 Per rilevare tutti i patogeni associati a un infezione, inclusi i ceppi non emolitici di streptococchi di gruppo B, è anche necessario inoculare con il campione un terreno agar sangue come BD Columbia Agar with 5% Sheep Blood. non è idoneo per l'isolamento degli streptococchi diversi da S. agalactiae o di altri patogeni in grado di causare infezioni simili (ad es. Listeria monocytogenes). Le prestazioni di questo terreno con i campioni di origine animale non sono state determinate. Caratteristiche prestazionali Una valutazione delle prestazioni è stata eseguita con 151 campioni clinici (tamponi vaginali e cervicali, vari campioni provenienti da neonati) giudicati positivi per S. agalactiae mediante inoculazione standard su piastra di agar sangue seguita dalla tipizzazione sierologica degli PA Pagina 3 di 5
4 isolati. 15 Di questi 151 campioni, 148 sono risultati positivi con la seconda coltura su BD Columbia Agar with 5% Sheep Blood e hanno prodotto un isolato non emolitico e 147 isolati beta-emolitici. Su, incubato in anaerobiosi per h, 149 dei 151 campioni hanno riportato crescita di streptococchi di gruppo B; di questi, 148 hanno riportato vari tipi di colonie colore arancio (sensibilità del 98%) che sono state tutte identificate sierologicamente come streptococchi di gruppo B. Di queste 148 colture, tre sono state classificate come arancio molto chiaro. Se si sottraggono queste tre colture, si ottiene una sensibilità del 96%. In questo studio, le piastre di BD Group B Streptococcus Differential Agar (Granada Medium) inoculate sono anche state incubate in atmosfera aerobica arricchita con anidride carbonica. In queste condizioni di incubazione, la sensibilità è risultata del 96,8%. Su queste piastre, 14 colture sono state classificate come arancio molto chiaro. Se si sottraggono queste colture, si ottiene una sensibilità dell'87,4%. Quando le piastre sono state incubate in anaerobiosi, si sono ottenuti molti più isolati con colonie di colore arancio intenso rispetto all'incubazione in atmosfera aerobica arricchita con anidride carbonica (P < 0,005). Inoltre, le colonie di molti ceppi sono risultate di dimensioni maggiori quando incubate in anaerobiosi. Quindi, l'incubazione in anaerobiosi migliora notevolmente la rilevazione delle colonie colore arancio. In questa valutazione sono stati anche inclusi 52 campioni precedentemente classificati come negativi per S. agalactiae. Con la coltura su BD Group B Streptococcus Differential Agar (Granada Medium) non si sono ottenuti falsi positivi (specificità = 100%). L'uso di migliora e rende più rapida la diagnosi di streptococchi di gruppo B e riduce i costi e i tempi di esecuzione rendendo inutili ulteriori test per l'identificazione delle colonie colore arancio. BIBLIOGRAFIA 1. Ruoff, K.L., R.A. Whiley, and D. Beighton. Streptococcus. In: Murray, P. R., E. J. Baron, J.H. Jorgensen, M. A. Pfaller, and R. H. Yolken (ed.). Manual of clinical microbiology, 8 th ed. American Society for Microbiology, Washington, D.C. 2. Schuchat, A Epidemiology of group B streptococcal disease in the United States. Clin. Microbiol. Rev. 11: Juncosa, T., et al Infeción neonatal por Streptococcus agalactiae. Estudio multicéntrico en el área de Barcelona. Enferm. Infecc. Microbiol. Clin. 16: Centers for Disease Control and Prevention Prevention of perinatal group B streptococcal diaease: a public health perspective. Morbid. Mortal. Weekly Rep. 45: Islam, A.K.M Rapid recognition of group B streptococci. Lancet I: de la Rosa, M., et al Granada medium for detection and identification of group B streptococci. J. Clin. Microbiol. 18: de la Rosa, M., et al New Granada medium for detection and identification of group B streptococci. J. Clin. Microbiol. 30: Reardon, E.P., et al Evaluation of a rapid method for the detection of vaginal group B streptococci in women in labor. Am. J. Obstet. Gynecol. 184: Overman, S.B., et al Evaluation of methods to increase the sensitivity and timeliness of detection of Streptococcus agalactiae in pregnant women. J. Clin. Microbiol. 40: de la Rosa-Fraile, M Granada agar sensitivity and detection of group B Streptococcus. Letter to the Editor. J. Clin. Microbiol. 41: Thomson, R.B., and J.M. Miller Specimen collection, transport, and processing: bacteriology. In: Murray, P. R., E. J. Baron, J.H. Jorgensen, M. A. Pfaller, and R. H. Yolken (ed.). Manual of clinical microbiology, 8th ed. American Society for Microbiology, Washington, D.C. 12. Spellerberg, B., et al Identification of genetic determinants for the hemolytic activity of Streptococcus agalactiae by ISS1 transposition. J. Bacteriol. 181: Pritzlaff, C.A., et al Genetic basis for the ß-haemolytic/cytolytic activity of group B Streptococcus. Molec. Microbiol. 39: Edwards, M. and J. Baker Streptococcus agalactiae. In: Mandell, G.I., et al. (eds.) Principles and practice of infectious diseases. New York Medical Publications, New York, p Dati in archivio. 2003; BD Diagnostic Systems Europe. Heidelberg, Germania. 16. Rosa-Fraile, M., et al Granadaene: proposed structure of the Group B Streptococcus polyenic pigment. Apppl. Environm. Microbiol. 72: PA Pagina 4 di 5
5 CONFEZIONE/DISPONIBILITÀ REF Terreni su piastra pronti per l'uso, confezioni da 20 ULTERIORI INFORMAZIONI Per ulteriori informazioni, rivolgersi al rappresentante BD di zona. Becton Dickinson GmbH Tullastrasse 8 12 D Heidelberg/Germany Phone: Fax: [email protected] ATCC is a trademark of the American Type Culture Collection BD, BD Logo and all other trademarks are property of Becton, Dickinson and Company BD PA Pagina 5 di 5
BD Modified CNA Agar BD Modified CNA Agar with Crystal Violet
 ISTRUZIONI PER L'USO TERRENI SU PIASTRA PRONTI ALL'USO PA-255082.02 Rev.: giugno 2003 BD Modified CNA Agar BD Modified CNA Agar with Crystal Violet USO PREVISTO BD Modified CNA Agar (agar CNA modificato)
ISTRUZIONI PER L'USO TERRENI SU PIASTRA PRONTI ALL'USO PA-255082.02 Rev.: giugno 2003 BD Modified CNA Agar BD Modified CNA Agar with Crystal Violet USO PREVISTO BD Modified CNA Agar (agar CNA modificato)
BD MacConkey II Agar / Columbia CNA Agar with 5% Sheep Blood (Biplate)
 ISTRUZIONI PER L'USO TERRENI SU PIASTRA PRONTI ALL'USO PA-254447.01 Rev.: giugno 2003 BD MacConkey II Agar / Columbia CNA Agar with 5% Sheep Blood (Biplate) USO PREVISTO BD MacConkey II Agar / Columbia
ISTRUZIONI PER L'USO TERRENI SU PIASTRA PRONTI ALL'USO PA-254447.01 Rev.: giugno 2003 BD MacConkey II Agar / Columbia CNA Agar with 5% Sheep Blood (Biplate) USO PREVISTO BD MacConkey II Agar / Columbia
PRINCIPI E SPIEGAZIONE DELLA PROCEDURA
 PA-254039.07-1 - ISTRUZIONI PER L'USO TERRENI SU PIASTRA PRONTI ALL'USO PA-254039.07 Rev.: April 2013 Glucose Agar Chloramphenicol Gentamicin and Chloramphenicol Penicillin and Streptomycin USO PREVISTO
PA-254039.07-1 - ISTRUZIONI PER L'USO TERRENI SU PIASTRA PRONTI ALL'USO PA-254039.07 Rev.: April 2013 Glucose Agar Chloramphenicol Gentamicin and Chloramphenicol Penicillin and Streptomycin USO PREVISTO
ISTRUZIONI PER L USO TERRENI DIPSLIDE PRONTI PER L USO DA Rev.: Sept BD BBL GO Slide
 ISTRUZIONI PER L USO TERRENI DIPSLIDE PRONTI PER L USO DA-273257.01 Rev.: Sept 2006 BD BBL GO Slide USO PREVISTO BBL GO Slide è un sistema di vetrini a due terreni per l isolamento di Neisseria gonorrhoeae
ISTRUZIONI PER L USO TERRENI DIPSLIDE PRONTI PER L USO DA-273257.01 Rev.: Sept 2006 BD BBL GO Slide USO PREVISTO BBL GO Slide è un sistema di vetrini a due terreni per l isolamento di Neisseria gonorrhoeae
BD Chocolate Agar (GC II Agar with IsoVitaleX) BD Chocolate Agar (Blood Agar No. 2 Base)
 PA-254060.06-1 - ISTRUZIONI PER L'USO TERRENI SU PIASTRA PRONTI ALL'USO PA-254060.06 Rev.: Sep 2011 BD Chocolate Agar (GC II Agar with IsoVitaleX) USO PREVISTO BD Chocolate Agar (GC II Agar with IsoVitaleX)
PA-254060.06-1 - ISTRUZIONI PER L'USO TERRENI SU PIASTRA PRONTI ALL'USO PA-254060.06 Rev.: Sep 2011 BD Chocolate Agar (GC II Agar with IsoVitaleX) USO PREVISTO BD Chocolate Agar (GC II Agar with IsoVitaleX)
BD BBL TM CHROMagar TM CPE
 ISTRUZIONI PER L USO TERRENO SU PIASTRA PRONTO ALL USO BD BBL TM CHROMagar TM CPE PA-257681.02 Rev.: Gennaio 2017 USO PREVISTO BD BBL CHROMagar CPE è un terreno cromogeno selettivo per lo screening utilizzato
ISTRUZIONI PER L USO TERRENO SU PIASTRA PRONTO ALL USO BD BBL TM CHROMagar TM CPE PA-257681.02 Rev.: Gennaio 2017 USO PREVISTO BD BBL CHROMagar CPE è un terreno cromogeno selettivo per lo screening utilizzato
Ed. 01 Marzo Rev. 1.0
 1 MICROBIOLOGY TERRENI DI COLTURA CROMOGENICII 2011 Ed. 01 Marzo 2010 Rev. 1.0 LICKSON S.r.l. Uffici Amm.vi e stabilimento: S.S. 189 (PA-AG) - C.da Pettineo, 90020 VICARI (PA) - ITALY Casella Postale 90025
1 MICROBIOLOGY TERRENI DI COLTURA CROMOGENICII 2011 Ed. 01 Marzo 2010 Rev. 1.0 LICKSON S.r.l. Uffici Amm.vi e stabilimento: S.S. 189 (PA-AG) - C.da Pettineo, 90020 VICARI (PA) - ITALY Casella Postale 90025
BD Schaedler Agar / Schaedler KV Agar, with 5% Sheep Blood (Biplate)
 ISTRUZIONI PER L'USO TERRENI SU PIASTRA PRONTI ALL'USO PA-254476.02 Rev.: giugno 2003 BD Schaedler Agar / Schaedler KV Agar, with 5% Sheep Blood (Biplate) USO PREVISTO BD Schaedler Agar / Schaedler KV
ISTRUZIONI PER L'USO TERRENI SU PIASTRA PRONTI ALL'USO PA-254476.02 Rev.: giugno 2003 BD Schaedler Agar / Schaedler KV Agar, with 5% Sheep Blood (Biplate) USO PREVISTO BD Schaedler Agar / Schaedler KV
BD CLED Agar / MacConkey II Agar (Biplate)
 PA-257562.01-1 - ISTRUZIONI PER L'USO TERRENI SU PIASTRA PRONTI PER L'USO PA-257562.01 Rev.: Jan. 2016 BD CLED Agar / MacConkey II Agar (Biplate) USO PREVISTO BD CLED Agar / MacConkey II Agar (Biplate)
PA-257562.01-1 - ISTRUZIONI PER L'USO TERRENI SU PIASTRA PRONTI PER L'USO PA-257562.01 Rev.: Jan. 2016 BD CLED Agar / MacConkey II Agar (Biplate) USO PREVISTO BD CLED Agar / MacConkey II Agar (Biplate)
BD CHROMagar Orientation Medium
 PA-257481.03-1 - ISTRUZIONI PER L'USO TERRENI SU PIASTRA PRONTI ALL'USO PA-257481.03 Rev.: Sep 2011 BD CHROMagar Orientation Medium USO PREVISTO BD CHROMagar Orientation Medium (terreno di coltura di orientamento
PA-257481.03-1 - ISTRUZIONI PER L'USO TERRENI SU PIASTRA PRONTI ALL'USO PA-257481.03 Rev.: Sep 2011 BD CHROMagar Orientation Medium USO PREVISTO BD CHROMagar Orientation Medium (terreno di coltura di orientamento
BD CHROMagar Orientation Medium / Columbia CNA Agar (Biplate)
 ISTRUZIONI PER L'USO TERRENI SU PIASTRA PRONTI ALL'USO PA-254489.02 Rev.: giugno 2003 BD CHROMagar Orientation Medium / Columbia CNA Agar (Biplate) USO PREVISTO BD CHROMagar Orientation Medium/Columbia
ISTRUZIONI PER L'USO TERRENI SU PIASTRA PRONTI ALL'USO PA-254489.02 Rev.: giugno 2003 BD CHROMagar Orientation Medium / Columbia CNA Agar (Biplate) USO PREVISTO BD CHROMagar Orientation Medium/Columbia
BD BBL CHROMagar Staph aureus
 ISTRUZIONI PER L USO TERRENI SU PIASTRA PRONTI PER L USO PA-257074.06 Rev.: Sep 2011 BD BBL CHROMagar Staph aureus USO PREVISTO BBL CHROMagar Staph aureus è un terreno selettivo per l'isolamento, la conta
ISTRUZIONI PER L USO TERRENI SU PIASTRA PRONTI PER L USO PA-257074.06 Rev.: Sep 2011 BD BBL CHROMagar Staph aureus USO PREVISTO BBL CHROMagar Staph aureus è un terreno selettivo per l'isolamento, la conta
Ed. 01 Febbraio Rev. 1.0
 1 MICROBIOLOGY TERRENI DI COLTURA CROMOGENICI 2009 Ed. 01 Febbraio 2009 Rev. 1.0 LICKSON S.r.l. Uffici Amm.vi e stabilimento: S.S. 189 (PA-AG) - C.da Pettineo, 90020 VICARI (PA) - ITALY Casella Postale
1 MICROBIOLOGY TERRENI DI COLTURA CROMOGENICI 2009 Ed. 01 Febbraio 2009 Rev. 1.0 LICKSON S.r.l. Uffici Amm.vi e stabilimento: S.S. 189 (PA-AG) - C.da Pettineo, 90020 VICARI (PA) - ITALY Casella Postale
BD Sabouraud GC Agar / CHROMagar Candida Medium (Biplate)
 ISTRUZIONI PER L'USO TERRENI SU PIASTRA PRONTI ALL'USO PA-254515.03 Rev.: giugno 2003 BD Sabouraud GC Agar / CHROMagar Candida Medium (Biplate) USO PREVISTO BD Sabouraud GC Agar / CHROMagar Candida Medium
ISTRUZIONI PER L'USO TERRENI SU PIASTRA PRONTI ALL'USO PA-254515.03 Rev.: giugno 2003 BD Sabouraud GC Agar / CHROMagar Candida Medium (Biplate) USO PREVISTO BD Sabouraud GC Agar / CHROMagar Candida Medium
LA RICERCA DI CAMPYLOBACTER NEGLI ALIMENTI, ISO :2006
 numero 3 dicembre 2007 LA RICERCA DI CAMPYLOBACTER NEGLI ALIMENTI, ISO 10272-1:2006 Alcune specie di Campylobacter (C. jejuni, C. coli, e C. lari) sono frequentemente identificate come agenti causali di
numero 3 dicembre 2007 LA RICERCA DI CAMPYLOBACTER NEGLI ALIMENTI, ISO 10272-1:2006 Alcune specie di Campylobacter (C. jejuni, C. coli, e C. lari) sono frequentemente identificate come agenti causali di
ISTRUZIONI PER L'USO TERRENI IN FLACONE PARZIALMENTE COMPLETI. BD Tryptic Soy Agar
 ISTRUZIONI PER L'USO TERRENI IN FLACONE PARZIALMENTE COMPLETI BD Tryptic Soy Agar BA-256665.02 Rev.: agosto 2003 USO PREVISTO BD Tryptic Soy Agar (agar soia triptico), fornito in flaconi, è un terreno
ISTRUZIONI PER L'USO TERRENI IN FLACONE PARZIALMENTE COMPLETI BD Tryptic Soy Agar BA-256665.02 Rev.: agosto 2003 USO PREVISTO BD Tryptic Soy Agar (agar soia triptico), fornito in flaconi, è un terreno
BD BBL CHROMagar MRSA*
 ISTRUZIONI PER L USO TERRENI SU PIASTRA PRONTI PER L USO PA-257308.01 Rev.: Dec 2005 BD BBL CHROMagar * USO PREVISTO BBL CHROMagar è un terreno selettivo e differenziale per la rilevazione qualitativa
ISTRUZIONI PER L USO TERRENI SU PIASTRA PRONTI PER L USO PA-257308.01 Rev.: Dec 2005 BD BBL CHROMagar * USO PREVISTO BBL CHROMagar è un terreno selettivo e differenziale per la rilevazione qualitativa
Gli esami colturali dei terreni: metodologie e metodiche a confronto
 Gli esami colturali dei terreni: metodologie e metodiche a confronto Dott. Davide Camposampiero IV Corso di Formazione Società Italiana Banche degli Occhi Torino, 10 Ottobre 2009 Background La cornea è
Gli esami colturali dei terreni: metodologie e metodiche a confronto Dott. Davide Camposampiero IV Corso di Formazione Società Italiana Banche degli Occhi Torino, 10 Ottobre 2009 Background La cornea è
TERRENI. Sia i terreni solidi che quelli liquidi possono essere: Elettivi + sostanze che favoriscono la crescita di alcuni batteri
 Lo sviluppo della batteriologia ha avuto inizio quando si è trovata la possibilità di coltivare i batteri in vitro nei terreni di coltura, contenenti sostanze capaci di mantenere la vitalità e di permettere
Lo sviluppo della batteriologia ha avuto inizio quando si è trovata la possibilità di coltivare i batteri in vitro nei terreni di coltura, contenenti sostanze capaci di mantenere la vitalità e di permettere
ISTRUZIONI PER L USO TERRENI DIPSLIDE PRONTI PER L USO DA Rev.: giugno BD BBL Mycoslide
 ISTRUZIONI PER L USO TERRENI DIPSLIDE PRONTI PER L USO DA-273157.00 Rev.: giugno 2003 BD BBL Mycoslide USO PREVISTO BBL Mycoslide è un dipslide a tre terreni per l individuazione di miceti, inclusi i lieviti,
ISTRUZIONI PER L USO TERRENI DIPSLIDE PRONTI PER L USO DA-273157.00 Rev.: giugno 2003 BD BBL Mycoslide USO PREVISTO BBL Mycoslide è un dipslide a tre terreni per l individuazione di miceti, inclusi i lieviti,
JAA 2010/07 Italiano. Terreno BBL in piastra pronto per l uso per la differenziazione di Escherichia coli. BBL MacConkey II Agar with MUG
 Terreno BBL in piastra pronto per l uso per la differenziazione di Escherichia coli BBL MacConkey II Agar with MUG USO PREVISTO Il terreno BBL MacConkey II Agar with MUG è usato per l identificazione presuntiva
Terreno BBL in piastra pronto per l uso per la differenziazione di Escherichia coli BBL MacConkey II Agar with MUG USO PREVISTO Il terreno BBL MacConkey II Agar with MUG è usato per l identificazione presuntiva
ISTRUZIONI PER L'USO TERRENI IN FLACONE PARZIALMENTE COMPLETI
 ISTRUZIONI PER L'USO TERRENI IN FLACONE PARZIALMENTE COMPLETI BA-257104.01 Rev.: agosto 2003 BD Sabouraud Glucose Agar USO PREVISTO BD Sabouraud Glucose Agar (agar Sabouraud con glucosio), fornito in flaconi,
ISTRUZIONI PER L'USO TERRENI IN FLACONE PARZIALMENTE COMPLETI BA-257104.01 Rev.: agosto 2003 BD Sabouraud Glucose Agar USO PREVISTO BD Sabouraud Glucose Agar (agar Sabouraud con glucosio), fornito in flaconi,
ANALISI MICROBIOLOGICHE DELLE ACQUE PER USO UMANO Ricerca di Escherichia coli
 numero 9 marzo 2009 ANALISI MICROBIOLOGICHE DELLE ACQUE PER USO UMANO Ricerca di Escherichia coli Appartenente alla famiglia delle Enterobacteriaceae, Escherichia coli è il batterio coliforme predominante
numero 9 marzo 2009 ANALISI MICROBIOLOGICHE DELLE ACQUE PER USO UMANO Ricerca di Escherichia coli Appartenente alla famiglia delle Enterobacteriaceae, Escherichia coli è il batterio coliforme predominante
ISTRUZIONI GENERALI PER L'USO Terreni di coltura pronti all'uso e parzialmente completati
 GENERAL.02 Rev.: July 2009 ISTRUZIONI GENERALI PER L'USO Terreni di coltura pronti all'uso e parzialmente completati Il presente documento fornisce informazioni sulla struttura dei documenti di Istruzioni
GENERAL.02 Rev.: July 2009 ISTRUZIONI GENERALI PER L'USO Terreni di coltura pronti all'uso e parzialmente completati Il presente documento fornisce informazioni sulla struttura dei documenti di Istruzioni
BBL Middlebrook 7H9 Broth with Glycerol
 BBL Middlebrook 7H9 Broth with Glycerol Rev. 12 ottobre 2015 PROCEDURE DI CONTROLLO DI QUALITÀ (Facoltativo) I II INTRODUZIONE Middlebrook 7H9 Broth with Glycerol è un terreno di coltura non selettivo
BBL Middlebrook 7H9 Broth with Glycerol Rev. 12 ottobre 2015 PROCEDURE DI CONTROLLO DI QUALITÀ (Facoltativo) I II INTRODUZIONE Middlebrook 7H9 Broth with Glycerol è un terreno di coltura non selettivo
BBL Trypticase Soy Agar with 5% Sheep Blood (TSA II) e BBL MacConkey II Agar with MUG- I Plate
 BBL Trypticase Soy Agar with 5% Sheep Blood (TSA II) e BBL MacConkey II Agar with MUG- I Plate Rev. 03 Aprile 2015 PROCEDURE DI CONTROLLO DI QUALITÀ I II INTRODUZIONE Trypticase Soy Agar with 5% Sheep
BBL Trypticase Soy Agar with 5% Sheep Blood (TSA II) e BBL MacConkey II Agar with MUG- I Plate Rev. 03 Aprile 2015 PROCEDURE DI CONTROLLO DI QUALITÀ I II INTRODUZIONE Trypticase Soy Agar with 5% Sheep
Terreno cromogeno in polvere e supplementi selettivi per la preparazione dei terreni CRE Medium ed ESBL medium.
 N 408025 CRE-ESBL BASE rev 2 05-2016 Pagina 1 di 5 ChromArt CRE-ESBL Base ChromArt ESBL Supplement ChromArt CRE Supplement Terreno cromogeno in polvere e supplementi selettivi per la preparazione dei terreni
N 408025 CRE-ESBL BASE rev 2 05-2016 Pagina 1 di 5 ChromArt CRE-ESBL Base ChromArt ESBL Supplement ChromArt CRE Supplement Terreno cromogeno in polvere e supplementi selettivi per la preparazione dei terreni
BD BBL UROTUBE BBL UROTUBE M BBL UROTUBE E BBL UROTUBE E. coli BBL UROTUBE SXT
 DA212115.03 Page 1 of 11 ISTRUZIONI PER L USO TERRENI DIPSLIDE PRONTI PER L USO DA212115.03 Rev.: Aug 2005 BD BBL UROTUBE BBL UROTUBE M BBL UROTUBE E BBL UROTUBE E. coli BBL UROTUBE SXT USO PREVISTO I
DA212115.03 Page 1 of 11 ISTRUZIONI PER L USO TERRENI DIPSLIDE PRONTI PER L USO DA212115.03 Rev.: Aug 2005 BD BBL UROTUBE BBL UROTUBE M BBL UROTUBE E BBL UROTUBE E. coli BBL UROTUBE SXT USO PREVISTO I
TERRENI DI DI C OLTURA COLTURA
 TERRENI DI COLTURA Definizione Si definisce Terreno di coltura il mezzo nel quale o sul quale può avvenire lo sviluppo e la crescita in vitro di un microrganismo Classificazione Definiti o sintetici Indefiniti
TERRENI DI COLTURA Definizione Si definisce Terreno di coltura il mezzo nel quale o sul quale può avvenire lo sviluppo e la crescita in vitro di un microrganismo Classificazione Definiti o sintetici Indefiniti
BD BBL CHROMagar Salmonella
 ISTRUZIONI PER L USO TERRENI SU PIASTRA PRONTI PER L USO Rev.: April 2013 BD BBL CHROMagar Salmonella Brevetto U.S.A. n. 5.098.832, 5.194.374 USO PREVISTO BBL CHROMagar Salmonella è un terreno selettivo
ISTRUZIONI PER L USO TERRENI SU PIASTRA PRONTI PER L USO Rev.: April 2013 BD BBL CHROMagar Salmonella Brevetto U.S.A. n. 5.098.832, 5.194.374 USO PREVISTO BBL CHROMagar Salmonella è un terreno selettivo
RISOLUZIONE OIV/ENO 329/2009
 RISOLUZIONE OIV/ENO 329/2009 CODEX LIEVITI SECCHI ATTIVI - Modificazione L ASSEMBLEA GENERALE, Visto l articolo 2 paragrafo 2 ii dell'accordo del 3 aprile 2001 che ha portato alla creazione dell'organizzazione
RISOLUZIONE OIV/ENO 329/2009 CODEX LIEVITI SECCHI ATTIVI - Modificazione L ASSEMBLEA GENERALE, Visto l articolo 2 paragrafo 2 ii dell'accordo del 3 aprile 2001 che ha portato alla creazione dell'organizzazione
1 a prova TAMPONE FARINGEO. - Faringite in pz di 30 anni - Streptococchi beta emolitici A, C, G. Ricerca di. Esame microscopico diretto
 PROVA PRATICA 1 a prova TAMPONE FARINGEO - Faringite in pz di 30 anni - Ricerca di Streptococchi beta emolitici A, C, G Esame microscopico diretto NO Esame colturale Terreni di coltura SI Agar sangue CNA
PROVA PRATICA 1 a prova TAMPONE FARINGEO - Faringite in pz di 30 anni - Ricerca di Streptococchi beta emolitici A, C, G Esame microscopico diretto NO Esame colturale Terreni di coltura SI Agar sangue CNA
PRINCIPI E SPIEGAZIONE DELLA PROCEDURA
 ISTRUZIONI PER L USO TERRENI DIPSLIDE PRONTI PER L USO DA-273191.00 Rev.: luglio 2003 BD BBL Dermatoslide USO PREVISTO BBL Dermatoslide è un sistema di vetrini a due lati per la rilevazione e l isolamento
ISTRUZIONI PER L USO TERRENI DIPSLIDE PRONTI PER L USO DA-273191.00 Rev.: luglio 2003 BD BBL Dermatoslide USO PREVISTO BBL Dermatoslide è un sistema di vetrini a due lati per la rilevazione e l isolamento
BD BBL CHROMagar Salmonella* / XLD Agar (Biplate)
 ISTRUZIONI PER L USO TERRENI SU PIASTRA PRONTI PER L USO PA-257372.02 Rev.: April 2013 BD BBL CHROMagar Salmonella* / XLD Agar (Biplate) * Brevetto U.S.A. n. 5.098.832, 5.194.374 USO PREVISTO BBL CHROMagar
ISTRUZIONI PER L USO TERRENI SU PIASTRA PRONTI PER L USO PA-257372.02 Rev.: April 2013 BD BBL CHROMagar Salmonella* / XLD Agar (Biplate) * Brevetto U.S.A. n. 5.098.832, 5.194.374 USO PREVISTO BBL CHROMagar
Sommario. L Autore e i Collaboratori. Presentazione. Introduzione. La microbiologia clinica
 v Sommario L Autore e i Collaboratori Presentazione Introduzione. La microbiologia clinica xi xiii xv La batteriologia clinica dalla teoria alla pratica in laboratorio: cenni storici 1 Capitolo I Caratteristiche
v Sommario L Autore e i Collaboratori Presentazione Introduzione. La microbiologia clinica xi xiii xv La batteriologia clinica dalla teoria alla pratica in laboratorio: cenni storici 1 Capitolo I Caratteristiche
Kit completi contenenti terreni di coltura pronti in piastra petri ø 60 mm + le membrane di filtrazione con reticolo, in confezione singola sterile.
 NUTRIENT PETRI AGAR (NPA) Kit completi contenenti terreni di coltura pronti in piastra petri ø 60 mm + le membrane di filtrazione con reticolo, in confezione singola sterile. I Kit completi (NPA) Nutrient
NUTRIENT PETRI AGAR (NPA) Kit completi contenenti terreni di coltura pronti in piastra petri ø 60 mm + le membrane di filtrazione con reticolo, in confezione singola sterile. I Kit completi (NPA) Nutrient
QUALITA MICROBIOLOGICA DEI COSMETICI: ASPETTI TECNICI E NORMATIVI CHALLENGE TEST
 QUALITA MICROBIOLOGICA DEI COSMETICI: ASPETTI TECNICI E NORMATIVI CHALLENGE TEST Convegno Biolife Sesto San Giovanni_Milano, 15 maggio 2015 Barbara Besostri Riferimenti per il challenge test Riferimento
QUALITA MICROBIOLOGICA DEI COSMETICI: ASPETTI TECNICI E NORMATIVI CHALLENGE TEST Convegno Biolife Sesto San Giovanni_Milano, 15 maggio 2015 Barbara Besostri Riferimenti per il challenge test Riferimento
DIAGNOSI DI LABORATORIO DELLE MALATTIE INFETTIVE
 DIAGNOSI DI LABORATORIO DELLE MALATTIE INFETTIVE L isolamento di un virus o di un batterio implica l impiego di particolari tecniche che richiedono giorni o settimane prima dell identificazione Ne consegue
DIAGNOSI DI LABORATORIO DELLE MALATTIE INFETTIVE L isolamento di un virus o di un batterio implica l impiego di particolari tecniche che richiedono giorni o settimane prima dell identificazione Ne consegue
Paolina Cavalcanti Daniela Perugini Saveria Dodaro
 Cosenza 18 giugno 2013 Paolina Cavalcanti Daniela Perugini Saveria Dodaro UOC Microbiologia e Virologia Direttore Dott.ssa Cristina Giraldi Esame microscopico a fresco Esame microscopico a fresco Esame
Cosenza 18 giugno 2013 Paolina Cavalcanti Daniela Perugini Saveria Dodaro UOC Microbiologia e Virologia Direttore Dott.ssa Cristina Giraldi Esame microscopico a fresco Esame microscopico a fresco Esame
Petrifilm Piastre per il conteggio di Enterobacteriaceae
 Guida all'interpretazione Petrifilm Piastre per il conteggio di Enterobacteriaceae 1 2 1 2 Conteggio di Enterobacteriaceae = 1 Il conteggio di Enterobacteriaceae è facile utilizzando le piastre Petrifilm
Guida all'interpretazione Petrifilm Piastre per il conteggio di Enterobacteriaceae 1 2 1 2 Conteggio di Enterobacteriaceae = 1 Il conteggio di Enterobacteriaceae è facile utilizzando le piastre Petrifilm
CANDIselect. Piastre cromogeniche
 CANDIselect Piastre cromogeniche Cromogeno di 2 a generazione Isolamento selettivo dei lieviti Inibizione dei batteri con Cloramfenicolo e gentamicina Identificazione diretta di Candida albicans Identificazione
CANDIselect Piastre cromogeniche Cromogeno di 2 a generazione Isolamento selettivo dei lieviti Inibizione dei batteri con Cloramfenicolo e gentamicina Identificazione diretta di Candida albicans Identificazione
REPORT VERIFICA POTERE ANTIMICROBICO
 UNIVERSITÀ DEGLI STUDI DI FERRARA / UNIVERSITY OF FERRARA DIPARTIMENTO DI MEDICINA SPERIMENTALE E DIAGNOSTICA / DPT. EXP. & DIAGNOSTIC MEDICINE SEZIONE DI MICROBIOLOGIA / SECTION OF MICROBIOLOGY via LUIGI
UNIVERSITÀ DEGLI STUDI DI FERRARA / UNIVERSITY OF FERRARA DIPARTIMENTO DI MEDICINA SPERIMENTALE E DIAGNOSTICA / DPT. EXP. & DIAGNOSTIC MEDICINE SEZIONE DI MICROBIOLOGIA / SECTION OF MICROBIOLOGY via LUIGI
Antibiogramma. Dott. Semih ESIN
 Antibiogramma Dott. Semih ESIN Antibiogramma: Indagine di laboratorio per saggiare la suscettibilità di un microrganismo ai farmaci antibatterici A causa della ormai vasta diffusione del fenomeno della
Antibiogramma Dott. Semih ESIN Antibiogramma: Indagine di laboratorio per saggiare la suscettibilità di un microrganismo ai farmaci antibatterici A causa della ormai vasta diffusione del fenomeno della
Urinocoltura : dal prelievo all antibiogramma
 Urinocoltura : dal prelievo all antibiogramma antibiogramma Dott.ssa Franca Benini U.O.Microbiologia Centro Sevizi Laboratorio Unico Pievesestina Forlì 17 maggio 2011 Il campione microbiologico: il percorso
Urinocoltura : dal prelievo all antibiogramma antibiogramma Dott.ssa Franca Benini U.O.Microbiologia Centro Sevizi Laboratorio Unico Pievesestina Forlì 17 maggio 2011 Il campione microbiologico: il percorso
BD Mueller Hinton II Agar BD Mueller Hinton II Agar 150 mm BD Mueller Hinton II Agar, Square
 PA-254032.07-1 - ISTRUZIONI PER L'USO TERRENI SU PIASTRA PRONTI ALL'USO PA-254032.07 Rev.: April 2013 BD Mueller Hinton II Agar BD Mueller Hinton II Agar 150 mm BD Mueller Hinton II Agar, Square USO PREVISTO
PA-254032.07-1 - ISTRUZIONI PER L'USO TERRENI SU PIASTRA PRONTI ALL'USO PA-254032.07 Rev.: April 2013 BD Mueller Hinton II Agar BD Mueller Hinton II Agar 150 mm BD Mueller Hinton II Agar, Square USO PREVISTO
Terreni di coltura Contenuto qualitativo (1 di 2)
 Terreni di coltura Terreni di coltura Terreno di coltura: mezzo nel quale o sul quale può avvenire lo sviluppo e la crescita in vitro di un microrganismo Caratteristiche: concentrazione adatta di sostanze
Terreni di coltura Terreni di coltura Terreno di coltura: mezzo nel quale o sul quale può avvenire lo sviluppo e la crescita in vitro di un microrganismo Caratteristiche: concentrazione adatta di sostanze
LE COLTURE BATTERICHE
 LE COLTURE BATTERICHE Per identificare un particolare microrganismo si utilizza la nomenclatura binomia ideata da Carlo Linneo. Tale tipo di nomenclatura è basata sul concetto di specie, che viene assunto
LE COLTURE BATTERICHE Per identificare un particolare microrganismo si utilizza la nomenclatura binomia ideata da Carlo Linneo. Tale tipo di nomenclatura è basata sul concetto di specie, che viene assunto
METODO PER LA RICERCA DI VIBRIO PARAHAEMOLYTICUS
 METODO PER LA RICERCA DI VIBRIO PARAHAEMOLYTICUS (FDA Modificato Edition 1995) INDICE 1. SCOPO E CAMPO DI APPLICAZIONE 2 2. RIFERIMENTI 2 3. PRINCIPIO DEL METODO 2 4. TERRENI DI COLTURA, REAGENTI E SIERI
METODO PER LA RICERCA DI VIBRIO PARAHAEMOLYTICUS (FDA Modificato Edition 1995) INDICE 1. SCOPO E CAMPO DI APPLICAZIONE 2 2. RIFERIMENTI 2 3. PRINCIPIO DEL METODO 2 4. TERRENI DI COLTURA, REAGENTI E SIERI
Faringite. Giovanni Di Bonaventura, Ph.D. CI Medicina di Laboratorio CL Medicina e Chirurgia Università G. d Annunzio di Chieti-Pescara AA 2014-2015
Faringite Giovanni Di Bonaventura, Ph.D. CI Medicina di Laboratorio CL Medicina e Chirurgia Università G. d Annunzio di Chieti-Pescara AA 2014-2015 Faringite Infiammazione del faringe, ipofaringe, ugole
Faringite Giovanni Di Bonaventura, Ph.D. CI Medicina di Laboratorio CL Medicina e Chirurgia Università G. d Annunzio di Chieti-Pescara AA 2014-2015 Faringite Infiammazione del faringe, ipofaringe, ugole
ALLU MARIA TERESA U.O.C. PATOLOGIA CLINICA 2 OTTOBRE
 ALLU MARIA TERESA U.O.C. PATOLOGIA CLINICA 2 OTTOBRE DIAGNOSI DI SEPSI: EMOCOLTURA rileva microrganismi vitali (batteri o funghi) coltivabili in vitro 1897 - Liebman descrive due casi di batteriemia 1906
ALLU MARIA TERESA U.O.C. PATOLOGIA CLINICA 2 OTTOBRE DIAGNOSI DI SEPSI: EMOCOLTURA rileva microrganismi vitali (batteri o funghi) coltivabili in vitro 1897 - Liebman descrive due casi di batteriemia 1906
La prevenzione ed il controllo delle infezioni delle vie urinarie
 La prevenzione ed il controllo delle infezioni delle vie urinarie Epidemiologia delle infezioni delle vie urinarie: i dati del laboratorio Dott.ssa Franca Benini Dott.ssa Giovanna Testa U.O.Microbiologia
La prevenzione ed il controllo delle infezioni delle vie urinarie Epidemiologia delle infezioni delle vie urinarie: i dati del laboratorio Dott.ssa Franca Benini Dott.ssa Giovanna Testa U.O.Microbiologia
Microrganismi Epower USO PREVISTO FORMULA E COMPONENTI SPECIFICHE E PRESTAZIONI
 Microrganismi Epower USO PREVISTO I microrganismi Epower sono preparati quantitativi liofilizzati di microrganismi da utilizzare in laboratori industriali per scopi di controllo di qualità. Si può utilizzare
Microrganismi Epower USO PREVISTO I microrganismi Epower sono preparati quantitativi liofilizzati di microrganismi da utilizzare in laboratori industriali per scopi di controllo di qualità. Si può utilizzare
ANALISI MICROBIOLOGICA DELLE ACQUE: CONFRONTO TRA IL METODO UNI/EN/ISO DEL 2014 E I METODI APAT-CNR-IRSA 7010C E 7030C DEL 2003.
 UNIVERSITÀ DEGLI STUDI DI TORINO SCUOLA DI MEDICINA DI TORINO CORSO DI LAUREA IN TECNICHE DI LABORATORIO BIOMEDICO TESI DI LAUREA ANALISI MICROBIOLOGICA DELLE ACQUE: CONFRONTO TRA IL METODO UNI/EN/ISO
UNIVERSITÀ DEGLI STUDI DI TORINO SCUOLA DI MEDICINA DI TORINO CORSO DI LAUREA IN TECNICHE DI LABORATORIO BIOMEDICO TESI DI LAUREA ANALISI MICROBIOLOGICA DELLE ACQUE: CONFRONTO TRA IL METODO UNI/EN/ISO
Le colture batteriche. Pievesestina 2010
 Le colture batteriche Pievesestina 2010 La riproduzione batterica: moltiplicazione cellulare La curva di crescita batterica: le fasi Numero di batteri Fase stazionaria Fase logaritmica di crescita Fase
Le colture batteriche Pievesestina 2010 La riproduzione batterica: moltiplicazione cellulare La curva di crescita batterica: le fasi Numero di batteri Fase stazionaria Fase logaritmica di crescita Fase
Tutti i casi di malattia invasiva batterica segnalazione rapida da parte dei clinici al Dipartimento di Sanità Pubblica dell Azienda USL
 La segnalazione Tutti i casi di malattia invasiva batterica: meningiti, sepsi, altre forme invasive batteriche sono eventi oggetto di segnalazione rapida da parte dei clinici al Dipartimento di Sanità
La segnalazione Tutti i casi di malattia invasiva batterica: meningiti, sepsi, altre forme invasive batteriche sono eventi oggetto di segnalazione rapida da parte dei clinici al Dipartimento di Sanità
MISURAZIONE DELL ATTIVITA' ANTIBATTERICA SU SUPERFICI PLASTICHE SECONDO METODO MUTUATO DALLA ISO 22196:2007
 laboratorio accreditato SINAL n 0051 Pag 1 di 7 MISURAZIONE DELL ATTIVITA' ANTIBATTERICA SU SUPERFICI PLASTICHE SECONDO METODO MUTUATO DALLA ISO 22196:2007 22/12/2008 laboratorio accreditato SINAL n 0051
laboratorio accreditato SINAL n 0051 Pag 1 di 7 MISURAZIONE DELL ATTIVITA' ANTIBATTERICA SU SUPERFICI PLASTICHE SECONDO METODO MUTUATO DALLA ISO 22196:2007 22/12/2008 laboratorio accreditato SINAL n 0051
AZIENDA OSPEDALIERO UNIVERSITARIA DI CAGLIARI. TERRENI DI COLTURA PER TEST MICROBIOLOGICI triennale CAPITOLATO TECNICO
 Allegato A AZIENDA OSPEDALIERO UNIVERSITARIA DI CAGLIARI Ospedale San Giovanni di Dio Policlinico Universitario Servizio di Farmacia direttore: dott.ssa Antonella Argiolu TERRENI DI COLTURA PER TEST MICROBIOLOGICI
Allegato A AZIENDA OSPEDALIERO UNIVERSITARIA DI CAGLIARI Ospedale San Giovanni di Dio Policlinico Universitario Servizio di Farmacia direttore: dott.ssa Antonella Argiolu TERRENI DI COLTURA PER TEST MICROBIOLOGICI
Aptima Multitest Swab Specimen Collection Kit
 Multitest Swab Specimen Collection Kit Aptima Uso previsto Aptima Multitest Swab Specimen Collection Kit (Kit di raccolta dei campioni di tampone Aptima Multitest) è utilizzabile con i test Aptima. Il
Multitest Swab Specimen Collection Kit Aptima Uso previsto Aptima Multitest Swab Specimen Collection Kit (Kit di raccolta dei campioni di tampone Aptima Multitest) è utilizzabile con i test Aptima. Il
Reg. (CE) 2073, punto 24 delle considerazioni preliminari
 I risultati delle analisi dipendono dal metodo analitico utilizzato; pertanto occorre associare ad ogni criterio microbiologico un metodo di riferimento specifico. Tuttavia, gli operatori del settore alimentare
I risultati delle analisi dipendono dal metodo analitico utilizzato; pertanto occorre associare ad ogni criterio microbiologico un metodo di riferimento specifico. Tuttavia, gli operatori del settore alimentare
LABORATORIO DI MICROBIOLOGIA. Presentato dalla classe 3^A CH
 LABORATORIO DI MICROBIOLOGIA Presentato dalla classe 3^A CH Analisi Ricerca lattobacilli in un campione di yogurt seminato su terreno MRS Ricerca degli streptococchi in un campione di yogurt seminato su
LABORATORIO DI MICROBIOLOGIA Presentato dalla classe 3^A CH Analisi Ricerca lattobacilli in un campione di yogurt seminato su terreno MRS Ricerca degli streptococchi in un campione di yogurt seminato su
